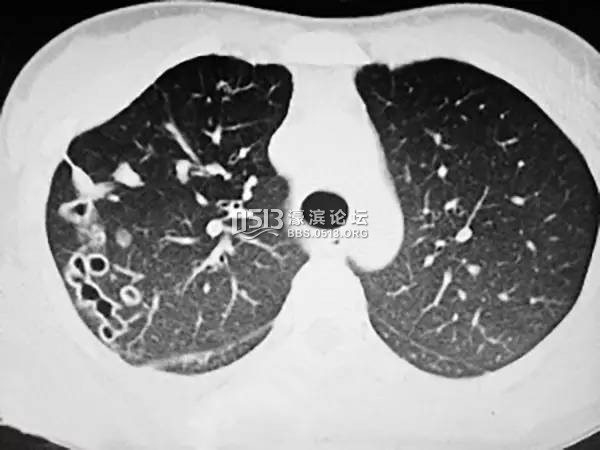
3b9f969e709e45709f58c24e669b28fd_th.jpg

- 阅读权限
- 60
- 精华
- 最后登录
- 1970-1-1
- 在线时间
- 小时
- 主题
- 好友
- 相册
- 分享
- 日志
- 记录
- UID
- 904404
- 帖子
- 0
TA的每日心情 | 慵懒
2014-1-7 10:37 |
|---|
签到天数: 2 天 [LV.1]初来乍到
|
咳血三年,23岁的小叶(化名)一直以为自己是得了肺结核,然而跑遍了大小医院,直到最近才查出是得了肺吸虫病。这一切根源于她的美食习惯:生吃螃蟹。专业医师说,喜欢生吃河鲜的人群都有可能被这种寄生虫“缠上”。
* U- ^& R- |) a8 J o' A! j8 Y! u6 P# s% ?5 z7 {! ?
咯血错当肺结核治了三年: M5 j5 r! p M4 O ]4 Q
& ?$ n* E$ o' D0 y- M; e
小叶从老家来浙江海宁打工好多年了,三年前,小叶忽然开始咳嗽,还伴有高烧情况,以为是支气管炎。她到当地医院就诊时,接诊医生发现小叶的症状更像是肺结核,便当作肺结核给予治疗。不过吃了一年多的肺结核治疗药物,咯血情况依然,小叶于是来到了杭州某诊疗中心就诊。
7 [: b' ?$ g. e- @7 g# a; r
0 c. `2 t% Q5 }: K8 |
0 c. `2 t% Q5 }: K8 |
接诊医生徐主任在拿到小叶的肺部CT片子后,发现小叶右肺上有明显的“隧道”,弯弯曲曲好几条。看起来并不像是一般结核病或者支气管炎患者的片子。对于肺吸虫病有过诊断经验的徐主任便问及小叶的饮食喜好,小叶回答,自己喜欢生吃河海鲜,尤其醉虾醉蟹。9 r! d2 O) I( i1 R& B; f J; T
4 X+ e1 [) E F9 D/ G ]) P “从她的影像报告,结合喜欢生吃螃蟹这一点,我估计肺里有寄生虫,不过还需要进一步的证据,”徐主任联系了杭州市疾控中心,让小叶做了吸虫抗体原检测,检查结果证实了徐主任的判断:小叶得了肺吸虫病。; M7 D y# d R; U
' S0 [4 V; m$ l2 x肺吸虫留下的“隧道”成永久创伤
/ t$ A6 y4 F' U% L( ?. T4 c" h7 e" N- ?7 g2 Q0 x
肺吸虫病是一种常见食源性寄生虫病,浙江等地区是肺吸虫病主要流行区域,以卫氏吸虫为主。肺吸虫的卵进入干净的淡水水源后会寄生到第一宿主川卷螺上,发育成尾蚴后脱离螺体入侵第二宿主如螃蟹、蝲蛄等节肢动物,发育成囊蚴,主要寄居在腮里。# W4 |- L1 w( N9 L* J8 @+ D7 t/ T
9 v3 x" d" Q, W' q# f$ R
徐主任说,如果人进食了生的带有肺吸虫囊蚴的河蟹、蝲蛄等河鲜,囊蚴会在肠壁上长成幼虫,随后便在人体组织游走入侵脏器。大部分是爬进肺里,也有在胸腔部位造成胸腔积液、心包积液。如果继续游走向上钻入大脑,会诱发癫痫等疾病。; C9 Y# ~( r2 D1 S/ O2 Z7 _ F! y
9 c; Y: x6 f5 ]0 j; _
肺吸虫可以在人体存活6-20年,并产卵,不过不会孵化,必须经过第一第二宿主才会成虫。( k9 s9 D3 |5 X/ L4 U
$ [2 c+ W. }9 W. [& n4 ]! c
最后,徐主任为小叶开具了抗肺吸虫的药物,小叶恢复很快。不过遗憾的是,从此以后肺上的这些“隧道”会永久留下,肺纤维化,功能减弱,咯血可能还会出现,并且更容易受到感染。
' P) ?& R4 R2 b6 D& H3 F- ~5 Q. A" }( o* I
少食生冷少饮生水,水产要煮熟再吃
( }8 y l4 {3 d& R9 f, n# c% S: r, n! W5 `
回想起来,小叶说自己曾咳出一口血痰,像是有虫子在其中,但当时不懂,以为自己就是痰中带血,加上初诊时的症状类似结核病,所以一直当做肺结核在治疗。2 v5 Q) v. E& y) ]
 6 c7 ^" [6 [/ L4 v1 y: I* m5 Q% b
6 c7 ^" [6 [/ L4 v1 y: I* m5 Q% b 徐主任说,感染肺吸虫的患者会出现咳嗽、呼吸困难、血痰、胸痛等典型症状,乍看之下与结核病极为相似,所以有50%的患者会被误诊为肺结核病。因此,出现类似症状的患者在就诊时要向医生详细说明自己的病史,如果喜欢生吃河海鲜,也要一起说明,这样有助于医生正确诊断病情。
9 H6 j" N: v: g' h: P6 K! }( L* p w% A; }' O8 c
“有一项指标可以作为参考,血常规检查单上如果显示嗜酸性粒细胞指数超标,像小叶的指数就是正常值的三倍。”徐主任说,如果这个指数有明显上升,并且有生吃海鲜习惯的人,最好及时找医生就诊,或者前往疾控中心做吸虫抗体抗原检测,以确诊是否感染肺吸虫病。
* G2 f* P) K8 S1 K3 D 徐主任提醒,腌制、醉酿等处理方式不能杀死肺吸虫,只有经过100℃高温沸水煮透才行。河鲜水产处理时,最好将腮清理干净,并且一定要煮熟煮透再吃。
& i& p/ d' H5 r( I& |南通0 |
|
 苏公网安备 32060202000307号 © 2001-2019 0513.org All Right Reserved.
苏公网安备 32060202000307号 © 2001-2019 0513.org All Right Reserved.